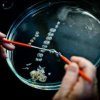

Parkinson’s disease is a progressive neurodegenerative disorder marked by the loss of dopamine-producing neurons in the brain. Since dopamine is involved in the regulation of movement and emotional affect, the loss of these neurons leads to deficits in motor activity and emotional response. Cellular therapies that aim to restore lost dopaminergic neurons hold promise for slowing the progression of Parkinson’s.
Researchers from Lund University in Sweden have published an article in Cell Stem Cell describing the generation of functional dopaminergic neurons from human embryonic stem cells. Led by Prof. Malin Parmar, the team differentiated dopaminergic neurons from human embryonic stem cells in culture, then transplanted them into the brains of rats that were modeled to exhibit the symptoms of Parkinson’s. Prof. Parmar and colleagues showed that following transplantation, the embryonic stem cell-derived dopaminergic neurons exhibited the functional characteristics of native dopaminergic neurons, including dopamine production as well as long distance extension and connection with target regions in the brain.
Given that there is currently no cure for Parkinson’s disease and that drugs and deep brain stimulation can lessen symptoms but not temper disease progression, the current study is viewed as a breakthrough. Unlike fetal stem cells, which have been previously used to create dopaminergic neurons, embryonic stem cells (from existing stem cell lines) offer an abundant, readily accessible supply of cells. Overall, the results of this study demonstrate an important pre-clinical proof of concept, with an estimated time to human trials set for approximately 3 years
source:Lund University
Researchers Transplant Functional Dopaminergic Neurons Derived from Human Embryonic Stem Cells